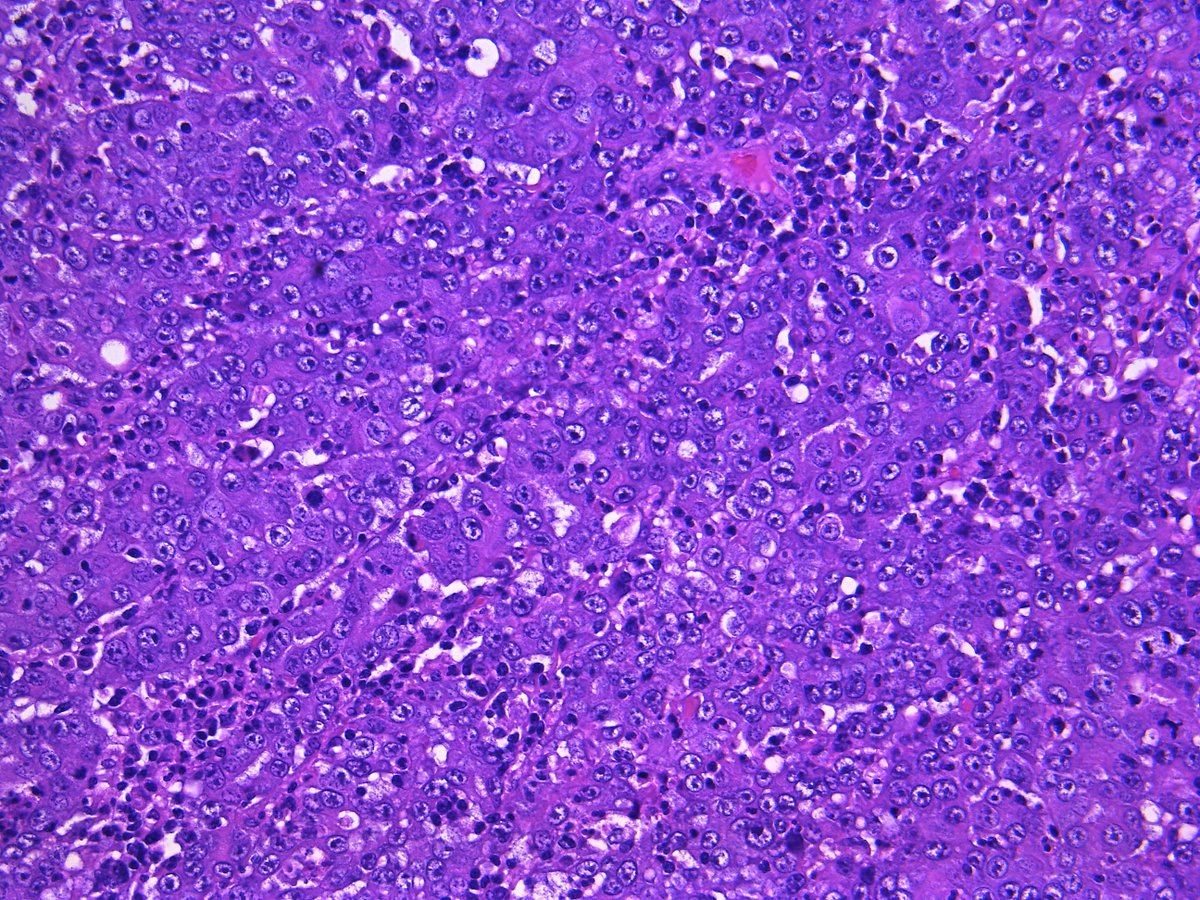
Pathology Walker@Auto Tweet Bot tweet media
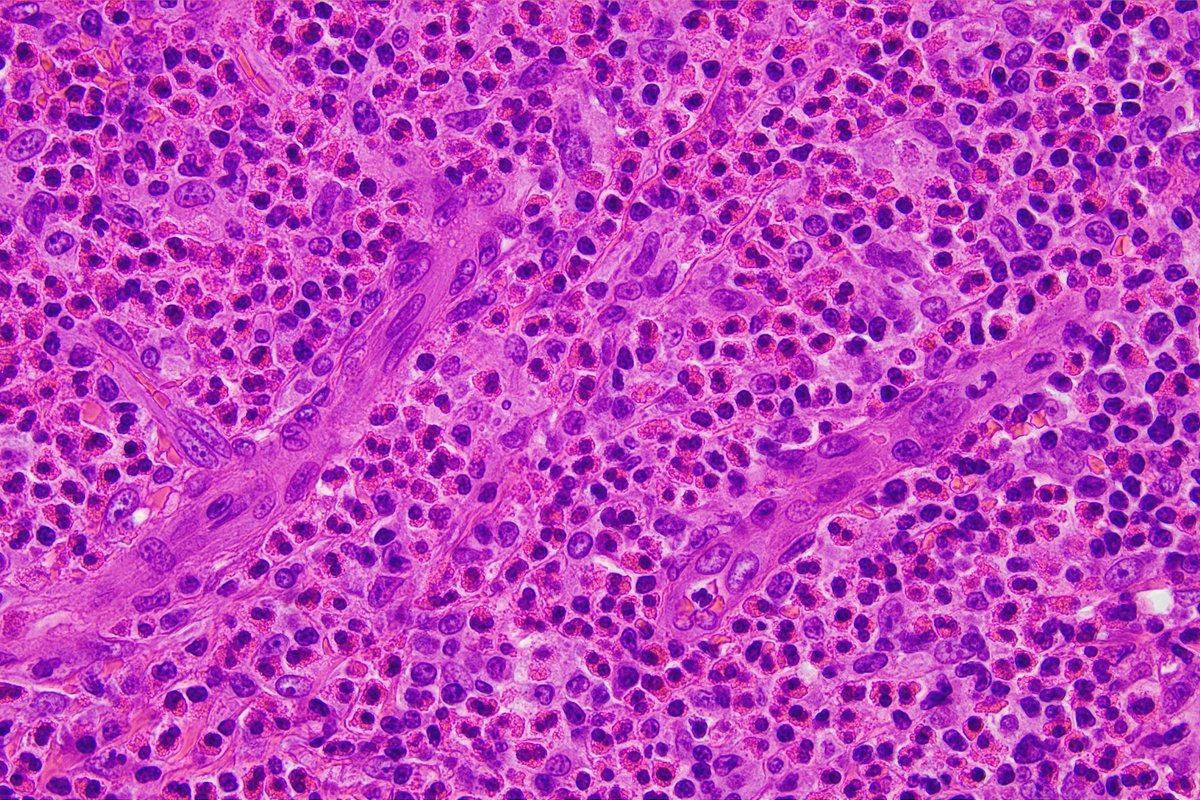
Pathology Walker@Auto Tweet Bot tweet media

Sabitlenmiş Tweet
Pathology Walker@Auto Tweet Bot
5.7K posts

Pathology Walker@Auto Tweet Bot
@Patholwalker
Twting Pathology, Histology&Endoscopy, sometimes Mushroom. My pics are All CR Free with quoting source as conditions. Please use the pics as much as you'd like.
Inside Microscope Katılım Temmuz 2017
2.6K Takip Edilen18K Takipçiler

Mismatch-repair deficient endometrioid carcinoma. HE and MLH-1(+), MSH-2(-), MSH-6(-), PMS2(+). Isthmus of uterus. #Pathology #Pathologist #GynPath

Indonesia

Amyloid cardiomyopathy. HE, Direct fast scarlet and Polarized light view #Pathology #Pathologist #CardiacPath




English

(Continued) Medulllary carcinoma of ascending colon. MLH-1, PMS2, MUC5AC and Ki-67 (MIB-1) . #Pathology #Pathologist #GIPath




English
Pathology Walker@Auto Tweet Bot retweetledi

Ruptured intracerebral cerebral aneurysm. Elastica van Gieson and Hematoxylin & eosin. #Pathology #Pathologist #NeuroPath




Română

Transthyretin amyloidosis, heart, biopsy. HE, Direct fast scarlet, Polarized light view, Amtloid transthyretin. #Pathology #Pathologist #CardiacPath




English

Papillary fibroelastoma of heart. HE, Elastica van Gieson, Gross. #CardiacPath #Pathology #Pathologist




English